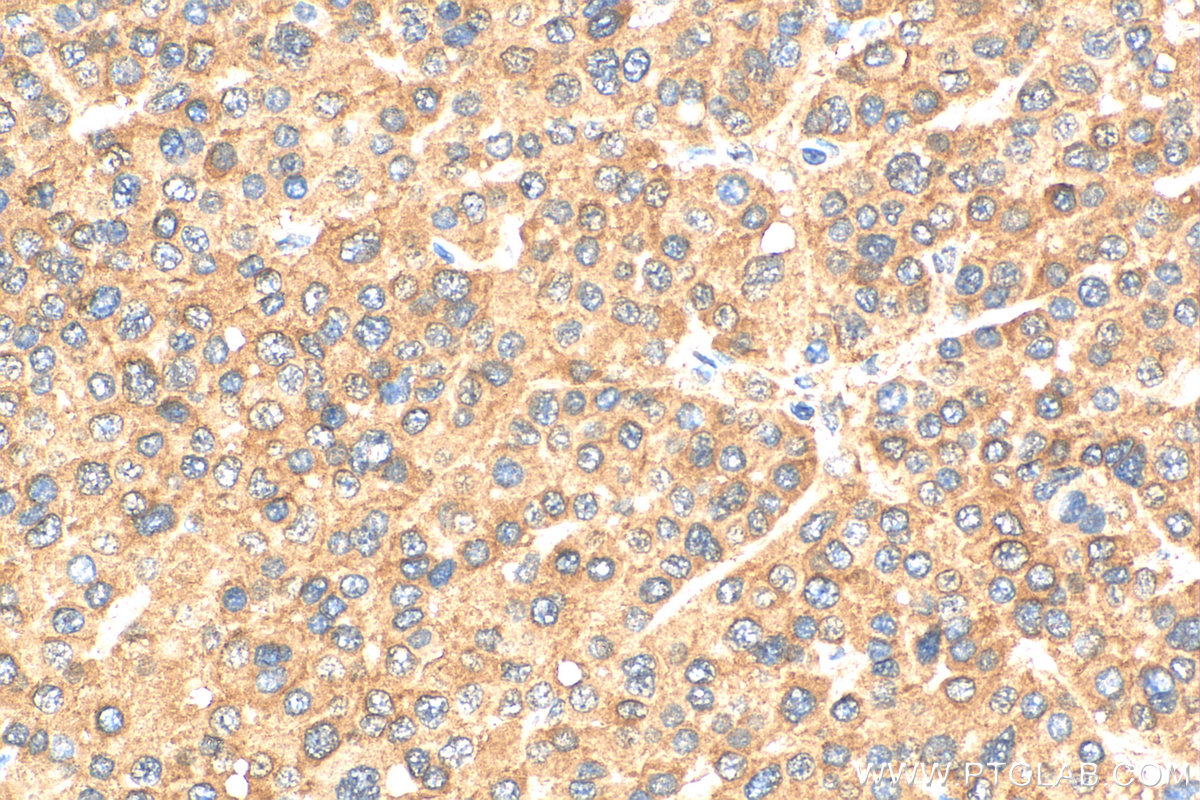
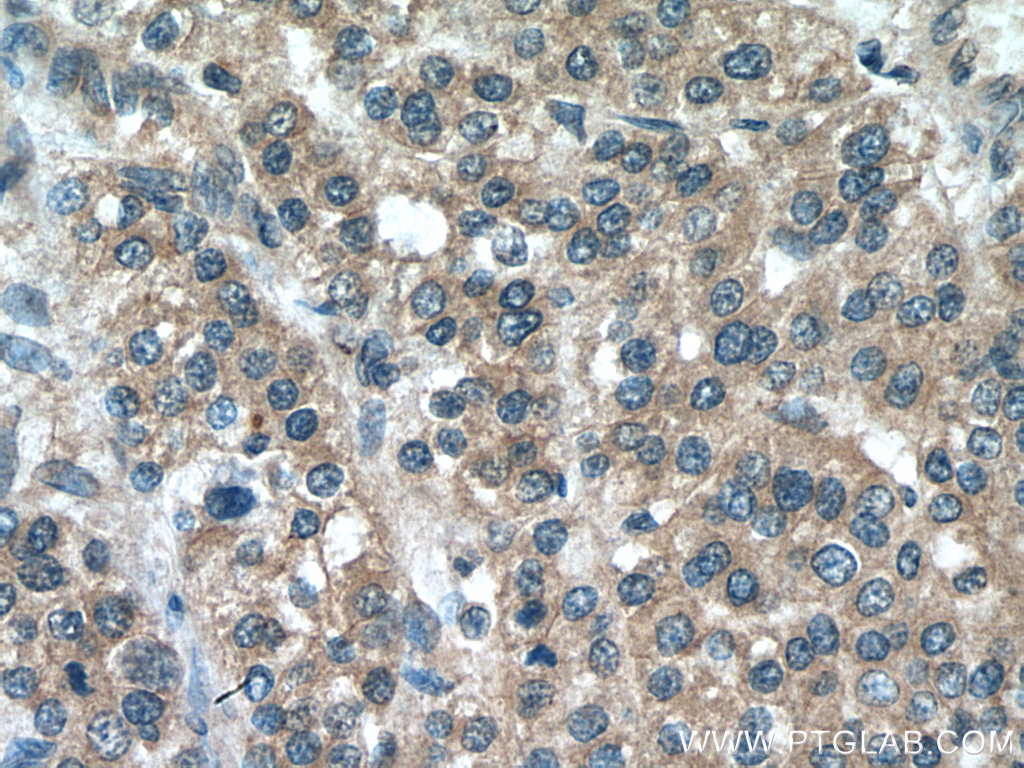

验证数据展示
经过测试的应用
| Positive IP detected in | HEK-293 cells |
| Positive IHC detected in | human liver cancer tissue, human colon tissue, mouse skeletal muscle tissue Note: suggested antigen retrieval with TE buffer pH 9.0; (*) Alternatively, antigen retrieval may be performed with citrate buffer pH 6.0 |
| Positive IF/ICC detected in | HepG2 cells |
推荐稀释比
| 应用 | 推荐稀释比 |
|---|---|
| Immunoprecipitation (IP) | IP : 0.5-4.0 ug for 1.0-3.0 mg of total protein lysate |
| Immunohistochemistry (IHC) | IHC : 1:50-1:500 |
| Immunofluorescence (IF)/ICC | IF/ICC : 1:20-1:200 |
| It is recommended that this reagent should be titrated in each testing system to obtain optimal results. | |
| Sample-dependent, Check data in validation data gallery. | |
产品信息
20276-1-AP targets LATS2-Specific in WB, IHC, IF/ICC, IP, CoIP, ELISA applications and shows reactivity with human, mouse samples.
| 经测试应用 | IHC, IF/ICC, IP, ELISA Application Description |
| 文献引用应用 | WB, IHC, IF, IP, CoIP |
| 经测试反应性 | human, mouse |
| 文献引用反应性 | human, mouse |
| 免疫原 |
Peptide 种属同源性预测 |
| 宿主/亚型 | Rabbit / IgG |
| 抗体类别 | Polyclonal |
| 产品类型 | Antibody |
| 全称 | LATS, large tumor suppressor, homolog 2 (Drosophila) |
| 别名 | LATS2, EC:2.7.11.1, KPM, LATS 2, Serine/threonine-protein kinase kpm |
| 计算分子量 | 120 kDa |
| 观测分子量 | 130-150 kDa |
| GenBank蛋白编号 | NM_014572 |
| 基因名称 | LATS2 |
| Gene ID (NCBI) | 26524 |
| RRID | AB_10697657 |
| 偶联类型 | Unconjugated |
| 形式 | Liquid |
| 纯化方式 | Antigen affinity purification |
| UNIPROT ID | Q9NRM7 |
| 储存缓冲液 | PBS with 0.02% sodium azide and 50% glycerol, pH 7.3. |
| 储存条件 | Store at -20°C. Stable for one year after shipment. Aliquoting is unnecessary for -20oC storage. |
背景介绍
LATS2, also named as KPM, belongs to the protein kinase superfamily and AGC Ser/Thr protein kinase family. LATS2 is a tumor suppressor which plays a critical role in centrosome duplication, maintenance of mitotic fidelity and genomic stability. It negatively regulates G1/S transition by down-regulating cyclin E/CDK2 kinase activity. It is a negative regulator of the androgen receptor. LATS2 has a calculated molecular mass of 120 kDa and an apparent molecular mass of 150 kDa (PMID: 10871863). The antibody is specific to LATS2.
实验方案
| Product Specific Protocols | |
|---|---|
| IF protocol for LATS2-Specific antibody 20276-1-AP | Download protocol |
| IHC protocol for LATS2-Specific antibody 20276-1-AP | Download protocol |
| IP protocol for LATS2-Specific antibody 20276-1-AP | Download protocol |
| WB protocol for LATS2-Specific antibody 20276-1-AP | Download protocol |
| Standard Protocols | |
|---|---|
| Click here to view our Standard Protocols |
发表文章
| Species | Application | Title |
|---|---|---|
Mol Cancer Co-transcriptional R-loops-mediated epigenetic regulation drives growth retardation and docetaxel chemosensitivity enhancement in advanced prostate cancer | ||
Cell Metab Cholesterol Stabilizes TAZ in Hepatocytes to Promote Experimental Non-alcoholic Steatohepatitis.
| ||
Cell Death Differ The Hippo signaling component LATS2 enhances innate immunity to inhibit HIV-1 infection through PQBP1-cGAS pathway.
| ||
Acta Pharmacol Sin Gracillin suppresses cancer progression through inducing Merlin/LATS protein-protein interaction and activating Hippo signaling pathway | ||
Clin Transl Med Tumor-derived exosomal miR-19b-3p facilitates M2 macrophage polarization and exosomal LINC00273 secretion to promote lung adenocarcinoma metastasis via Hippo pathway. | ||
Oxid Med Cell Longev miR-25 Promotes Cell Proliferation, Migration, and Invasion of Non-Small-Cell Lung Cancer by Targeting the LATS2/YAP Signaling Pathway. |